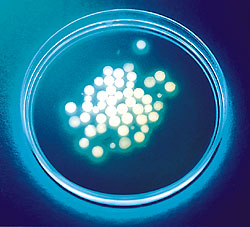

| CATEGORII DOCUMENTE |
| Bulgara | Ceha slovaca | Croata | Engleza | Estona | Finlandeza | Franceza |
| Germana | Italiana | Letona | Lituaniana | Maghiara | Olandeza | Poloneza |
| Sarba | Slovena | Spaniola | Suedeza | Turca | Ucraineana |
DOCUMENTE SIMILARE |
||||
|
||||
TERMENI importanti pentru acest document |
||||
| : | ||||


Content
Introduction
Biomaterials:We have the technology
Flexing alloy muscles
Ceramic on the Verge
Polymers and Tissue Engineering
Surface modification changes the game
Nanotechnology is here.sort of
The bionic boomers
Biometric strategies
Tissue engineering
Hubrid materials
Self-organisation and Ordered structures
Protein engineering
Sensor technologies
Implantable cells
New BIOMATERIAL is available to support living nerve cells
Smart Legos
Biomaterials: Body part of the future
Heart valve materials
Orthopedic biomaterials
Biomaterial laboratory missions
Biomaterials in 3rd dimension
Low pressure processes
High Pressure Rheology and the Impact on Process Homogeneity
OPTICAL DIAGNOSIS SYSTEMS FOR MEASURING THERMOFLUID DYNAMICALS PHENOMENA IN LIQUID BIOSYSTEMS UNDER ULTRA HIGH PRESSURE
EXPERIMENTAL METHODS
Evaluation of Metallic and Polymeric Biomaterial Surface
Energy and Surface Roughness Characteristics for Directed Cell Adhesion
Cell culture
Jet impingement
Conclusions
Introduction
Biomaterials: We Have the Technology The biomaterials market stands on the cusp of technological breakthroughs.
|
|
|
Biomaterials like nitinol have had an unprecedented effect on the market. |
The biocompatible materials market is estimated to
reach nearly $11.9 billion by 2008.1Biomaterials are used in every
medical device meant for body contact, from orthopedic implants and bone grafts
to coronary stents and soluble sutures.
Any device that needs to
function in connection with a biological system must display properties of
biocompatibility and biodurability
A
biomaterial, which is often made from an alloy, a ceramic, or a polymer, must
display traits of biocompatibility, meaning that it does not elicit a negative
response. Biomaterials must also display biodurability, meaning that they
resist wear or corrosion.
The characteristics of
durability and compatibility have long been associated with biomaterials. But
recently, manufacturers and researchers have been able to create and market
materials that contain a third property bioactivity.
Materials that incorporate bioactivity work in some way to enhance the healing
process.
|
|
|
New processing techniques have opened the door for ceramic-on-ceramic implants. |
Todays biomaterials are sealed into a collagen bag that isolates the material from the body. We ask, for example, if normal, vascularized healing could be induced by biomaterials of the future. Nonetheless, researchers continue to make promising advances to improve the use of bioresorbables, natural materials, engineered tissues, and nanotechnology. This introduction discusses materials currently on the market, and it examines the upcoming trends in biomaterials that could change the industry
Flexing Alloy Muscles
|
|
|
Morgan Advanced Ceramics ( |
More than other biomaterials, metals have corrosion
issues. As an implant wears, metal ions are introduced to the body. There is
some speculation that those ions may have unpredictable results at a molecular
level. Getting FDA approval when introducing a new alloy
therefore might be more difficult than getting approval for other materials.
Thats why alloys are less likely to be used in newer biomaterial devices. Even
so a metal such as titanium can be every bit as biocompatible as a polymer.
One alloy has gone far beyond
what we think of as traditional metals. Since its initial use in military
applications, nitinol has exploded in the medical marketplace, and with good
reason. Nitinol belongs to a class of shape-memory
alloys. It contracts when its heated, whereas standard metals usually expand
when heated. It is also super-elastic and produces 100 times greater thermal
movement (expansion, contraction) than standard metals.
These properties contribute to
nitinols common use in ballooning stents and catheters, in guidewires, and in
orthodontic arch wires for braces.
But nitinol offers more than just shape memory. He explains that beyond thermal
and mechanical properties, nitinol has magnetic resonance (MR) compatibility.
The magnetic susceptibility of nitinol is closer to that of titanium than of
stainless steel, Because of this, you can determine the exact dimensions of the
device, and it wont interfere with the image of the vessel. However not all
nitinol devices act the same way; it depends on the geometry of the device.
|
|
|
Polymer scaffolds like these from OBI ( |
Even more importantly there is a risk that a
magnetic response could actually move the device, and nitinol has properties
that help resist that movement. There are ASTM standards that demand all stents
have protection against such movements. It may be easier to meet those
requirements with nitinol than with stainless steel.
Nitinol manufacturers are
taking steps to improve biocompatibility through engineered surface
preparation. You cant just throw nitinol in the body and expect it to perform.
The nitinol must develop a passive surface layer through mechanical and
electrochemical engineering. Researchers have found that an oxide surface can
convince the body that the stent is part of its normal mechanics.
Nitinol does have limits, but
suppliers are working to stretch those limits where possible. A big topic right
now is fatigue performance. Medical manufacturers are using follow-up studies
to see how the devices are behaving. What happens is that owing to bending,
extension, compression, and torsion that occurs once a stent is deployed, many
stents end up broken. And until now, that possibility had not been considered
at the design level.
There have been no adverse effects reported in connection with a fracture. Nonetheless many designer sare learning more about these physiological conditions to improve stent durability. The next generation of nitinol will have a larger threshold.
Ceramics on the Verge All-ceramic
orthopedic implants are used widely in Europe and
|
|
|
A microscopic image shows how a stent coating from
SurModics ( |
But ceramics may also hold enormous potential for
orthopedic implants. And the advent of better quality control, new processing
techniques, and improved chemistry has alleviated much of the risk of fracture
in ceramics. Newer material compounds could also offer increased benefits for
ceramic implants.
Research from LLUSM has shown that
alumina-on-alumina bearings can run in serum for 20 million cycles, the
equivalent of 20 years in a patient. Ceramic-on-ceramic is the best option for
hip and knee replacement. Alumina-on-alumina is more than 1000 times more wear
resistant than the polyethylene bearings
Alumina-based ceramics were
not as advanced when they were first introduced in the 1970s, but the
technology has since gotten much better. For example, grain size has been
reduced. Todays alumina ceramics are engineered to have grains that are
between 1 and 4 m
Ceramics are better today is because of quality control. Batch samples used to
be destruct-tested. Now each part is proof-tested to twice the pressure it
would need to withstand in the human body.
Ceramics manufacturers also
employ hot isostatic pressing processes that close the pores to reduce
brittleness.Because of these improvements, none of the ceramic-on-ceramic
implants that have been implanted during the last six years have fractured.
LLUSM is also running studies on a 75% alumina
and 24% zirconia compound. Zirconia is about twice as strong as alumina, adding
that it can withstand 50,000-lb loads, but has caused some problems when
processed incorrectly. In 1999, a company changed its manufacturing process
from a batch furnace to a continuous conveyor furnace. The change exposed
weaknesses in zirconias chemical structure, making it more susceptible to
fracture. By combining it with alumina, those weaknesses are alleviated, and
the resulting compound is very strong and wear resistant.
Another ceramic product
that is available is an implant made of an oxygen-enriched composite material
of zirconium metal with a zirconia ceramic surface. The ceramic surface is 5 m
thick.
New processing techniques
could allow more- complex shapes, and more importantly, encourage more
economical use of the ceramic.
Polymers and Tissue Engineering
|
|
|
Oxinium from Smith & Nephew ( |
Because polymers are popular with device
manufacturers, their suppliers get the lions share of the biomaterials market.
In 2003, polymer sales accounted for more than $7 billion, almost 88% of the
entire market for that year.
The reasons for such
popularity are obvious. Polymers are cheapespecially when compared with alloys
and ceramics. They are also more flexible. Polymers can pretty much be built to
accommodate whatever trait the manufacturer needs. Certain polymers exhibit
toughness but also maintain the elasticity of a plastic. They can also be
designed to have increased lubricity.
Of course, not all polymers
are approved as biomaterials, but the ones that are used frequently in hip and
knee implantsultra-high-molecular-weight polyethylene, and
polyetheretherketone (PEEK), for examplecombine toughness for load-bearing or
high-impact applications and enough lubricity to reduce wear.
The most recent trend for biomaterials is in
tissue engineering. Tissue engineering represents a new phase for biomaterials.
A lot of the hardware that has been used, even though it lasts for decades,
cannot necessarily be used forever. So the dream of tissue engineering or
regenerative medicine is to develop treatments that will last a lifetime.
So far, the dream is being
realized with scaffold seeding. The process involves attracting or impaling
cells to grow within a biodegradable scaffold material. As the scaffold
degrades, the cells are released and take over the structure. The process may
speed healing, but more importantly, it eliminates the need for additional
surgeriesfor implant removal or replacement.
Polymers are attractive for
resorbable applications because you dont have leftover pieces. They serve
their function while the tissue is healing, but once the healing is finished,
the material goes away. According to Niederauer, when degradable polymers are
used, there is less concern about encapsulation, corrosion, or continuing
surgeries.
Surface Modification Changes the
Game
Coatings are a
panacea for biomaterials; they can help normal materials achieve qualities of
biocompatibility, biodurability, and bioactivity. Coatings and surface
modifications serve, in some ways, to trick the body into accepting a foreign
material, since the body only reacts to the surface of an object. Many manufacturers are attaching chemicals to or changing the shape of
the material surface. Even modifying the electric charge on the surface of a
biomaterial can convince surrounding tissues to accept an implant. The right
surface can impart properties such as lubricity, hemocompatibility, and
corrosion and wear resistance. Coatings can also be formulated for drug
elution, tissue engineering, and biocompatibility.
There is a lot of interest
in coating to improve biocompatibility. A hydrophilic polymer coating, for
example, works in several ways. It mimics the structure and function of a cell
wall, so water molecules will attach to it. So when the body sees the device,
it sees this layer of water on it, which does not elicit any response because
the body is used to seeing things like that. In essence, the body gets tricked
into thinking the device is normal. Hydrophilic polymer also increases
lubricity and can be altered to attract albumin or other biologics that
encourage cell growth.
Hydrophilic polymer, may be the most popular coating.
These days, its almost standard.
Thrombolitic or
blood-compatible coatings, such as heparin, are becoming quite common. Some
coatings are cell repellingin other words, the cells discourage a fibrin
buildup around an implant. At the same time, cell-attractive coatings or
surface-modification techniques are being used to allow devices to form a
closer bond with surrounding tissue. And, of course, drug-delivery coatings can
help in a variety of ways by eluting localized pharmaceuticals.
Applying a coating is much like painting a wall, although its a much more
involved process.
The finished coating
should be both flexible and strong. It must also have an even thickness and
should be able to be processed at near-room temperatures. The process becomes too
difficult when temperatures have to be very high.
The good thing about coatings is that they can be defined independently. That
is, the same device can be used in a different way depending on the coating
applied. What people have found over time is that its very difficult to get
desired physical properties and biological properties in one material. So you either have to sacrifice
the physical properties, or you have to sacrifice the surface properties. But
if you can put a coating on something, then you can get both.
Of course, not all
surface modifications are coating processes. Etching and chemical manipulation
can also introduce beneficial properties to a device.
|
|
|
Titanium and polymer surfaces are engineered at nanoscale
for the Thoratec ( |
Components are made by transforming the original metal surface. In other words, their surface is not a coating; the metal device is chemically altered to form a different material. The diffusional gradient under the oxide creates a gradual transition in mechanical properties from the oxide to the metal. Unlike the abrupt change in strain behavior characteristics of overlay coatings, this transition zone along with the nanostructural nature of the oxide enhances oxide adherence. Each component is oxidized to produce a ceramic surface approximately 5 m thick and then burnished to produce an articular surface. Its at least as smooth as that of a cobalt-chrome component
Nanotechnology Is Here . . . Sort
of Contrary to popular
belief, nanotechnology is not just a dream for the future. Modern biomaterials
science makes excellent use of nanotechnology and has done so for 30 or more
years. Todays biomaterials involve control of surface structures and
immobilized biomolecules at the nanometer scale. Surface modifications, such as
aligning molecules on a scaffold to better attract healing cells in the body,
are already a nanoscale process.
The lure of nanotechnology
lies in its flexibility. By going down to a nanoscale, you can improve the
properties, make them smoother, more wear resistant,
or more like the tissues surrounding the area.
Nanotech applications that are currently on the market or have been
demonstrated in the lab are very exciting. A current practice
of putting silver particles into burn dressings because of silvers
antimicrobial properties. Titanium nanoparticles have been used in
sunscreens. And gold nanoprobes may soon be used as DNA markers.
However, those who expect a fully rendered nanodevice or implant may have a
long wait ahead, So far, there are very few commercial nanotechnology
applications.

The Bionic Boomers
Of course, there is
always the chance that a new, and possibly more-effective, material may never
be introduced in the market. And there are several good reasons why. For one,
there are strict regulatory requirements when introducing a new product. New
materials must be thoroughly assayed for safety, according to FDA. Meeting FDA
demands often means spending thousands of dollars on clinical and preclinical
trialsand thats just for the material. After the material is approved, there
are still device studies that must be conducted.
Even
so, if a new material or coating has the potential to vastly improve the
healing process or patient quality of life, the benefits for manufacturers
often outweigh the risks. The growing aging population will drive companies to
take chances on introducing superior materials. There is quite a bit of money
to be made. The baby boomer population is very demanding. They want to remain
active, and they want to look good. That means a phenomenal amount of resources
funneled into quality of life.
Biomimetic Strategies
A biomimetic strategy acknowledges that in vivo processing of materials offers lessons in how problems should be approached. Bioactive components can be based on biopolymers, such as collagen, and various inorganic materials such as calcium phosphate and carbonate. We are coming to understand how nature builds calcium carbonate into complex, tough structures such as shells using biopolymers as fibres in the composite

Tissue Engineering
There are two broad strategies for tissue engineering. A materials-based approach relies on the appropriate cells organising automatically and correctly to produce new tissue, such as attempting to create large cellular masses by growth of cells on a synthetic polymer substrate. The. biological approach looks to use cues or signals to direct the assembly of cells and its responses into a particular organisation. The first strategy is effective for fabricating tissues where the microscopic structure is less critical, as in auricular cartilage or in structures such as tubes where the cell layers involved form natural, stable boundaries. The central feature of the biological approach is providing spatial, directional and rate-limiting signals or cues for cells developing in vitro. Regulatory cues can be chemical, mechanical, topographical features of the substrate and/or electromagnetic forces. This biological approach provides greater potential to produce complex, multilayered tissues, the possibility of synthesising complex architectures (for example, the minimum requirement in tendon and ligament replacements must be a parallel, axially aligned collagen fibre structure), and a control of the interface between different cell types to produce either adherence or gliding.
 [Tissue
[Tissue
Hybrid Biomaterials
A high degree of ordering, as found in single crystals, is an important structural theme in the development of hybrid (bio)materials. That is the route to enhanced physical properties and is also the background to the exciting progress being made on self-assembly and self organisation
Self-Organisation and Ordered Structures
Self-organisation is a major theme for generating ordered structures. Molecules called cyclic octapeptides can self-organise to form regular nanotubes. These beautiful nanotubes can self-assemble inside lipid membranes to function as efficient ion transport channels - such channels may be pharmacologically very useful as potential vehicles for drug delivery into living cells. The sol-gel process for the synthesis of porous ceramics can provide xerogels containing oriented cylindrical pores, and a range of micro- and mesoporous oxide materials can be synthesised with well-defined structures and with pore size radii varying from 0.5-2.0nm or up to 20nm with alternative processing techniques. Ceramic or ceramic-coated membranes may well make their mark in clinical applications in the near future.
PROTEIN ENGINEERING
Implantable silica-gel microspheres encapsulate active cells, protecting them from the body's immune system while allowing them to produce needed biological compounds
Many biomaterials have potential applications
in slightly different but overlapping disciplines. The same basic polymer used
for controlled drug release might also hold potential as a scaffolding material
for supporting the growth of tissueparticularly when seeded with appropriate
morphogenic compounds. The information gained from investigating the mechanisms
of cell attachment and endothelialization, for example, might yield useful
insights into the nature of nonthrombogenic coatings or tissue sealants. A case
in point is Protein Polymer Technologies (
Sensor Technologies
The identification of sensors as an important theme coincides with the rapid development of sensor technologies. Early warning is a clinical requirement, but requires sensitive and reliable measurements of relatively small changes over a relatively long time scale. Medical applications of newly formulated acoustic sensors include ultrasonic Doppler calibration, foetal monitoring, diagnosis and long-term monitoring of osteoporosis, all polymer two dimensional microimaging arrays for diagnostic purposes, non-invasive surgery, shock wave lithotrophy treatment, and focused high energy ultrasound treatment for cancer.
IMPLANTABLE CELLS
There may be another way around this problem, however. Several biotech companies have achieved some success in encasing living cells in a protective medium that withstands implantation while allowing passage of the substances naturally produced by those cellsnot an actual organ but perhaps the next best thing. The most obvious use for this approach would be in insulin delivery, and indeed most of the companies working in this area are investigating pancreatic islets and organic media

New biomaterial is able to support living nerve cells

This peptide-based scaffold, on which neurons grow fibers to communicate with each other and establish functional synapses, may be the longsought ideal medium for growing replacement nerve cells for victims of spinal cord injuries and other forms of nerve damage. New biological materials based on the tiny protein linkages called peptides will become increasingly important in developing approaches for a wide range of innovative medical technologies, including controlled drug release, new scaffolds for cell-based therapies, tissue and biomineralization

This is the first peptide-based biomaterial of its kind that can be designed at the molecular level. Although parts of animal cells such as collagen can be extracted as a basis for growing cells, such animal-derived materials may carry and pass on viruses to the attached growing cells. In contrast, the new peptide-based material is not extracted from animal cells.
And unlike other synthetic materials, these peptides are completely biological. They are composed of amino acids, which are the building blocks of all proteins. The peptides do not evoke an immune response or inflammation in living animals, and they can be used for a variety of applications. The reason this material is so interesting and unique is that we can individually tailor it to grow virtually every type of cell in the body.
SMART LEGOS
Fragments of the 80,000-plus kinds of proteins in our bodies are called peptides. Peptides transform themselves like tiny smart Legos into millions of essential substances. Dr. Zhang and other scientists have recently discovered that these same peptides can be tweaked into forming completely new natural materials that may be able to perform a variety of useful functions inside and outside the body. Researchers have found that peptides can self-assemble into non-protein-like structures such as fibers, tubules, sheets and thin layers. They can be made responsive to changes in acidity, mechanical forces, temperature, pressure, electrical and magnetic fields and light. They are stable.

Figure 3.
The peptide scaffold structure is analyzed by scanned electon microscopy (magnification 60,000X). Higher magnification reveals interwoven sapeptide nanofibers that are approximately 10-20 nm in diameter
Biomaterials: Body Parts of the Future
During the last 90 years, man-made materials and devices have been developed
to the point at which they can be used successfully to replace parts of living
systems in the human body. These special materials able to function in
intimate contact with living  tissue,
with minimal adverse reaction or rejection by the body are called biomaterials.
Devices engineered from biomaterials and designed to perform specific functions
in the body are generally referred to as biomedical devices or implants.
tissue,
with minimal adverse reaction or rejection by the body are called biomaterials.
Devices engineered from biomaterials and designed to perform specific functions
in the body are generally referred to as biomedical devices or implants.
The earliest successful implants were bone plates, introduced in the early 1900s to stabilize bone fractures and accelerate their healing. Advances in materials engineering and surgical techniques led to blood vessel replacement experiments in the 1950s, and artificial heart valves and hip joints were under development in the 1960s 1] As early as the first bone plate implants, surgeons identified material and design problems that resulted in premature loss of implant function, as evidenced by mechanical failure, corrosion, and poor biocompatibility. Design, material selection, and biocompatibility remain the three critical issues in todays biomedical implants and devices. As advances have been made in the medical sciences, and with the advent of antibiotics infectious diseases have become a much smaller health threat. Because average life expectancy has increased, degenerative diseases are a critical issue, particularly in the aging population. More organs, joints, and other critical body parts will wear out and must be replaced if people are to maintain a good quality of life. Biomaterials now play a major role in replacing or improving the function of every major body system (skeletal, circulatory, nervous, etc.)..
Heart Valve Materials
The science of replacing organs or parts of organs that are crucial to our existence is both exciting and potentially dangerous. Success can mean years of healthy living; failure can mean death. An example of the successful development of a critical implant technology is the artificial heart valve. Although poor heart valve designs resulted in clinical failures in the past, the current limiting factor for long-term success is the materials themselves
|
|
Artificial mechanical heart valves are made of pyrolytic carbon to prevent complications associated with blood clotting, but his material can be subject to cyclic fatigue. The Institute has developed an acoustic emission-based system for detecting crack initiation and the growth of existing flaws during controlled stress testing of artificial heart valves. |
Orthopedic Biomaterials
Imagine that you are a 65-year-old woman who has suffered from chronic hip pain for the last 10 years because of degenerative arthritis. Able to walk only with difficulty and losing your independence, you turn to an orthopedic surgeon for help. Or, you are a 30-year-old man who cannot walk without experiencing unbearable knee pain as a result of a football injury sustained in high school, and are restricted from any form of athletics except swimming. In cases such as these, when improvement cannot be gained through physical therapy, nonsurgical treatments, or surgical repairs, orthopedic surgeons often advised joint replacement surgery in which the deteriorated joint is removed and replaced with a man-made device.
|
Bone plates, introduced in the early 1900s to assist in the healing of skeletal fractures, were among the earliest successful biomedical implants. The plate is generally removed once the bone has healed and the bone can support loads without refracturing. |
|
|
|
The wrist joint is a complicated one, allowing flexion, extension, adduction, and abduction, primarily through the radiocarpal joint. Though not subject to the severe wear problems encountered in other orthopedic implants, artificial wrist joints will benefit from improved biomaterials, particularly those designed to incorporate biological factors to enhance bone attachment, as well as materials with improved mechanical integrity and corrosion resistance. |
Biomaterial Laboratory Missions The aim of the Biomaterials Laboratory is to develop biomaterials and implantable devices that may contribute to the restoration of tissue architecture and function, especially of bone, to alleviate the consequences of disease, ageing and trauma.

Biomaterials in the 3rd dimension

Services and products
Prototype manufacturing (e.g. instrument shells) and engineering services for medical instrument technology.

Non-toxic polymers featuring innovative mechanical properties for stereolithography process.
Patient-specific design and manufacture of implants and surgery templates from various medically applicable materials, from individual components to small series production.

Customized anatomical planning models, in particular for oral and maxillo-facial surgery. Optionally available featuring realistic soft tissue properties or coloured surfaces as well as marked interior structures in transparent models.
Medical data preparation for surgical planning and implant design.

Prototyping systems (stereolithography, 3D printing, vacuum casting), equipment for the
development, manufacture and analysis of ceramic and polymer biomaterials provide the
basis for attractive services and successful research.

Low pressure processes
Low pressure gas-discharge plasmas are widely used for polymer surface functionalization on industrial scale. For biomaterial applications, the density and selectivity of the functionalization are of particular importance, because functional groups control the immobilization of biomolecules. Therefore, surface modification of biomaterials is a challenging task for low-pressure plasma technique. Plasma processes have been successfully applied to various polymer types in order to generate multi functional surfaces. This paper discusses the present state and the prospects of non-coating plasma processes to generate mono functional surfaces of controlled amino group density. Such surfaces appear most desirable for many applications. The results of various microwave- (MW) and radiofrequency-(RF) excited plasma processes reported in the literature are reviewed and compared to a sequence of experiments that was conducted in a UHV reaction environment. Anisothermal plasmas are especially well suited for thermally damageable polymers. The effect of hydrogen admixture to discharges in nitrogen and ammonia is discussed in detail.The optimization of process parameters lead to highly selective amino functionalization of high density. The selectivity reached 100 % NH2/N at a surface density of amino groups of 3 % NH2/C.
High Pressure Rheology and the Impact on Process Homogeneity
By treatment of matter with pressures up to 1000 MPa, forces in the order of molecular scale are induced, which can significantly alter the thermophysical properties of liquids. Especially the dynamic viscosity is strongly affected by pressure in the considered range in comparison to density or heat conductivity. In case of oils the change in value can amount a factor hundred and more. This influences the transport of mass, momentum and energy in the high pressure vessel and therefore the homogeneity of the processed media. Hereby, product quality and safety of foods are concerned. On the other hand side, by in-situ viscosity measurements, pressure induced structural reversible and irreversible changes of the sample can be detected. This contribution deals with the influence of pressures up to 700 MPa on the viscous behaviour of liquid biomaterials. Furthermore, the impact of the viscous behaviour under pressure on the homogeneity of high pressure processes is presented. For viscosity measurements a rolling ball viscosimeter and a vibrational rheometer are applied. Process homogeneity is investigated by numerical simulation of a high pressure process in a 30 l vessel using the commercial finite volume program ANSYS CFX 10. Own extension of the code allow the implementation of pressure and temperature dependent physical properties. From the investigated liquid biomaterials, oils show the strongest dependence of viscosity on pressure in the measured range. While oils, sugar solutions and gelatine characterize a reversible behaviour, the aqueous-Lactoglobulin solutions change in structure irreversibly due to pressure induced aggregation of the whey proteins. The latter effect is detected by a noticeable increase in viscosity. During the considered high pressure processes transient, spatial viscosity inhomogeneities arise in the autoclave.

OPTICAL DIAGNOSIS SYSTEMS FOR MEASURING THERMOFLUID DYNAMICALS PHENOMENA IN LIQUID BIOSYSTEMS UNDER ULTRA HIGH PRESSURE
Pressure is a fundamental thermodynamic quantity, comparable to temperature or chemical potential. Thus, the result of application of sufficiently high pressures in bioprocesses proves to be extremely manifold. This reveals pressure as basic tool for fundamental research, for specific biostructure creation and bioprocess design. As a consequence of this, research in the field of high pressure treatment of biomaterials has become recently to an extremely promising and, therefore, worldwide very dynamically developing discipline. Most progress has been achieved in food and biosciences but other disciplines such as medicine have also recognized the high potential of high pressure treatment meanwhile.
In most of the papers in literature the description of biophysical and chemical effects under high pressure occurs assuming validity of thermodynamics for homogeneous matter at rest. It could be shown experimentally and theoretically that this postulation does not hold [1]. In fact, compression is always connected to a forced convection. Furthermore, compression under practical (non-isotherm) conditions generates thermal diffusion and, thus, natural convection in liquid biomaterials. Altogether, it must be stated that the pressurization processes are always heterogeneous even in the case of homogeneous matter available.
EXPERIMENTAL METHODS
For visualization of velocity and temperature fields
microencapsulated thermochromic liquid crystals are used while they can reflect
selectively light as a function of temperature. Furthermore, in [ it was shown for the first time that the wave length of
the reflected light also depends on the pressure. Finally, the liquid crystals
used are also well suitable as tracer. Thus, they allow determining the temperature
distribution by illuminating the liquid crystals with white light and analyzing
the reflected light (color or wavelength). Additionally, this
facilitate the determination of the velocity field via Particle Image
Velocimetry (PIV). The main experimental setup consists of a tempered high pressure
optical cell having a volume of 2 ml, which is equipped with sapphire windows
of 6 mm optical width. This high pressure cell is designed to bear pressures up
to 700 MPa. This system is illuminated by a sheet of white light from a xenon
lamp. The field is recorded by a fixed 3-chip RGB ( Red-Green-Blue)
CCD camera which is located at a right angle to the incident light sheet. This
reflected light is first expressed as
RESULTS
Figure 2 and 3 illustrates typical results obtained for the temperature and velocity field in water during pressure induced phase transition to the Ice I conformation [3]. For this process the cell is first cooled down to 263 K and then pressurized to 120 MPa. Then the temperature of the temper bath is set to a temperature around 278 K.
 Figure
2: Phase transition of Ice I under high pressure (150 MPa)
Figure
2: Phase transition of Ice I under high pressure (150 MPa)
In Figure 2 the diffuse streak corresponds to the transition front whereby the rigid phase is placed in the upper part. The blue color corresponds to the higher temperature which decreases with increasing wave length. Thus, red indicate the smallest temperature whereby the detectable temperature difference between blue and red is 1.3 K. This demonstrates the excellent temperature resolution of HPDPIT. Figure 2 also clearly demonstrates the heterogeneity of temperature distribution in the liquid phase. Most remarkable is the cold spot located in the upper right part. In this context it must be taken into consideration that temperature strongly influences biophysical and chemical processes. Furthermore, the effect of high pressure on microorganisms is strong function of temperature
.

 Figure3:Convective process during melting of Ice I
Figure3:Convective process during melting of Ice I
Figure 3 illustrates convection during melting of ice. This process starts by melting of ice near the wall region where temperature is maximal. In the presence of liquid ice detaches from the inner wall of the cell. Ice I moves up because of its density is lower than that of water. Movement of the ice block forms two counter rotating vortices in the water layer below it. These vortices have accelerative effect on heat
convection: the liquid from near wall region is carried near to the solid-liquid surface and phase transition develops. In PIV image solid body motion can be differentiated with the area located in the upper part of the figure. In the lower fluid part, substantial convection is observed. This is contradictory to the pure diffusive effect of a system in rest assumed in literature. Thus, results for biophysical and chemical as well as microbiological effects obtained yet have to be checked taking into consideration the coupled momentum and energy transfer found in experiments. Furthermore, the design of high pressure chamber for practical applications of high pressure on biomaterials must include the occurring convective transport processes.
CONCLUSIONS
HP-DPIT and HP-DPIV, originally developed for diagnosing temperature and velocity fields in pure one-phase liquids under high pressure, have been further adapted to a method for High Pressure Digital Phase Transition Detection (HP-DPTD). The latter has been shown to be suitable for detecting the transition front as well as the temperature and velocity distribution in its neighborhood. The results found show conclusively that neither the assumption of homogeneity nor of pure diffusive transport in a resting liquid holds. As biosystems are very sensible against mechanical and thermal heterogeneities results published yet are worth to be checked carefully.

Evaluation of Metallic and Polymeric Biomaterial Surface
Energy and Surface Roughness Characteristics for Directed Cell Adhesion
CURRENT TISSUE ENGINEERING TECHNOLOGIES to direct cell adhesion through surface-linked adhesion proteins, hydrogel layers, and surface treatments are approaching clinical use. However, quantitative relationships of how the underlying surface characteristics affect adhesion remain incomplete. Underlying surfaces may ultimately be exposed upon removal of surface treatment layers over the long term. There-fore, it remains important to know the inherent cell adhesion properties of all implant materials including those with modified surfaces. Poor biomaterial performance is often caused by nonintegration of the implant with surrounding tissue or infection.1 Post-operative tissue integration and infections are influenced by the relative ability of bacteria and autologous cells (e.g., fibroblasts, osteoblasts, etc.) to adhere and colonize biomaterial surfaces. The ability to engineer directed cell responses to material surfaces is dependent upon a clear understanding of how different surface characteristics on various biomaterials affect implant cell interactions. This understanding is prerequisite for optimizing scaffolding and implant surface performance.Previously, we reported that an optimum range of surface charge was associated with maximal adhesion to metallic biomaterial surfaces.2 In this investigation, we hypothesized that, similar to surface charge, an optimal range of surface energy and surface roughness may be associated with maximal cell adhesion and colonization on polymeric and metallic biomaterials. Cellular adhesion strength was determined by jet impingement.Colonization characteristics of biomaterial surfaces were investigated by measuring cell proliferation as well as relative amounts and composition of the extracellular matrix (ECM) secreted by fibroblasts.

Cell culture
3T3 Fibroblasts (BALB/c clone A31, American Type Culture
Collection CCL 173) were cultured in Dulbeccos modified Eagles medium (DMEM),
and supplemented with 10% fetal bovine serum (FBS) and gentamicin, to form a
subconfluent monolayer on the metals stainless steel (316L), cobalt-chromium
alloy (HS25, F-75), titanium alloy (Ti-6Al-4V), and tantalum (Ta) and the
nonmetals glass Corning tissue culture petri dishes, polytetrafluoroethylene
(PTFE), silicone rubber (SR), and high-density-polyethylene (HDPE). All
examples except glass petri dishes were obtained from Metal Samples Company (

Jet impingement
When the cells were nearly confluent, the Petri dish containing the sample was transferred to a constant temperature bath at 37C. A submerged laminar jet of 37C phosphate-buffered saline (PBS, Gibco) solution (Reynolds no. < 1750) was directed at the cells grown on the surfaces of the various materials to create a lesion in the cell layer. The jet issued from a nozzle oriented perpendicular to the cell layer, from a height of 2.514 mm (four times the nozzle diameter, 0.6285 mm). The cell layer was subjected to the flow for 30 s, a time period previously established Deshpande et al.4 The shear stresses at the perimeter of the lesions created by the flow were determined according to the theory of Deshpande and Vaishnav.4 Knowingthe size of the lesion and using published nondimensionalized stress versus radial distance calibration curves,5 the stresses required to erode the cells off the material surface were determined. Images of each lesion were digitally captured and processed to find Ts, the applied shear stress, at
the perimeter of the lesion, according to methods previously described.3 Ts is a quantitative measure of the shear strength with which cells adhere to surfaces.25 Two glass petri dishes were used as controls in each measurement series to ensure the comparability of the data sets.The lesions were detected under ultraviolet light after exposure to a solution of 5% fluorescein diacetate (Sigma Chemical Co.) in 70% acetone (Sigma Chemical Co.) mixed with phosphate-buffered saline (PBS) (Gibco) in the proportion of 5% stain to 95% saline.2,3 Photographs of the lesions were taken and then digitized with an Abaton 2000 black and white scanner. The areas of the lesions were then calculated using NIH Image 1.51, image processing software. Four lesions were created on each disk, one in each quadrant. The stress field for a given lesion rapidly decays with distance from the needle axis, i.e., the stresses are negligible ( 0.1% of max) beyond 3 cm from the nozzle which is an open area encompassed within a single quadrant. Thus, the flow to create a given lesion did not affect the cells used in the adjacent areas where subsequent lesions were made. This procedure was repeated at least twice for each material, yielding a minimum of eight lesions for each material.

Surface energy
Total surface energy and the dispersive and polar components of surface energy for 316L, HS25, Ti-6Al-4V, Ta, glass, PTFE, and SR, were determined from contact angle measurements using six liquids on each material: PBS, glycerin, 30W-oil, DMEM, dimethylsulfoxide (DMSO), and benzene. The experimental procedures used for determination of solid/liquid/gas interfacial contact angles followed those of Andrade et al.7 A series of eight drops (2 mL/drop) were placed on the samples, and the contact angle, u, was measured using a digital camera (Connectix QuickCam) connected to the eyepiece of an inspection zoom microscope (Bausch and Lomb StereoZoom 7). Images were acquired by a laptop computer (Apple, Duo 280) and u determined using NIH Image image processing software, through measurement of the height and width of drops placed on the biomaterial surface. A series of at least eight drops were used in two trials, for a total of 16 contact angle measurements per liquid on a particular material surface. To determine the components of polar (acid/base) and dispersion surface tensions of material surface A and liquid B according to the analysis of Schakenraad et al the Young-Dupre equation.
CONCLUSIONS
Efforts to produce directed cell adhesion responses to biomaterial interfaces requires the ability to alter surface characteristics (e.g., surface energy and roughness) for desired cellular proliferation and adhesion. Rather than finding an optimal range of adhesion associated with surface roughness and surface energy, as originally hypothesized, complex trends were observed regarding the relation between surface energy, sur-regression applies to all data. face roughness, and fibroblast adhesion. Materials of lower surface energy (i.e., polymers) showed an increase in cellular adhesion strength associated with increased surface roughness, whereas materials of higher surface energy (i.e., metals) demonstrated little change in cellular adhesion strength with increased surface roughness. Overall, surface energy was a more influential surface characteristic than surface roughness on cellular adhesion strength and proliferation. The surface energy components of the various materials tested (HS25, 316L, Ti-6Al-4V, Ta, glass, SR, and PTFE) were shown to be related to cellular adhesion strength. However, the cellular adhesion strength associated with the metallic materials exceeded the cohesion strength of cell membranes. Differences in specific ECM proteins were shown to exist between materials of high and low adhesion strength as well as differences in the general amounts of ECM deposition, with greater amounts of ECM/cell secreted on materials of low adhesion strength (i.e., polymers). TEM observations showed larger gaps between cell and substrate on low-adhesion materials (polymers). Therefore, manipulating surface energy may be a more effective strategy for directing cell adhesion responses, whereas alterations in roughness through microtexturing techniques may be more effective on polymeric surfaces than on inherently highly adhesive metallic biomaterials.

The Future of Biomaterials
Biomaterials research is an exciting and rapidly growing field. Lawsuits against medical device manufacturers, restructuring of FDA approval procedures, patient expectations, and the health care reform movement are changing the future of the medical device community and shaping the direction of biomaterials research. For example, lawsuits have prompted long-term material suppliers and device manufacturers to refuse the use of their products in medical applications. As a result, new materials and suppliers will be required to meet FDA standards. Another important issue not often discussed is that implant recipients expect an implant to function as well as its biological counterpart, and to last forever. This misconception has been fostered by the popular press and some physicians, and will only be corrected by properly educating potential recipients.
Biomaterials and implant research at SwRI will continue to concentrate on serving the needs of medical device manufacturers and recipients, as well as medical professionals, and on developing technologies to meet those needs. Future biomaterials will incorporate biological factors (such as bone growth) directly into an implants surface to improve biocompatibility and bioactivity. New projects will be directed at materials development for improved mechanical integrity, corrosion resistance, and biocompatibility. Institute engineers will also apply statistical finite element analysis, stereoimaging strain analysis, and composite materials to the biomaterials program.
|
Politica de confidentialitate | Termeni si conditii de utilizare |

Vizualizari: 2930
Importanta: ![]()
Termeni si conditii de utilizare | Contact
© SCRIGROUP 2026 . All rights reserved